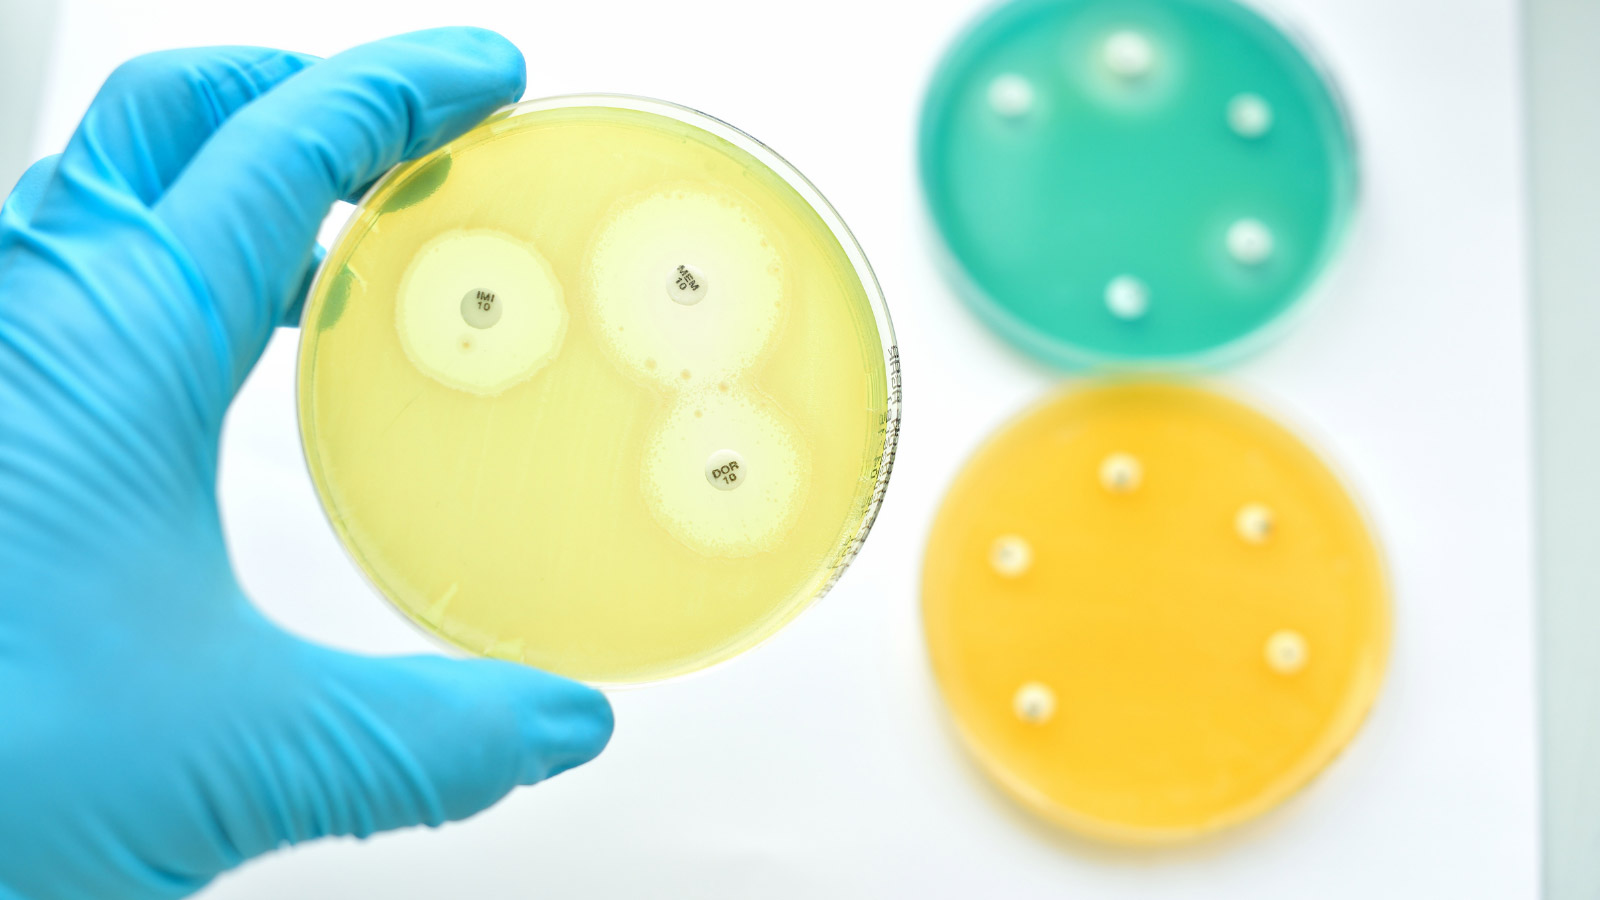
apid detection and effective infection control system for antimicrobial resistance

Rapid Detection and control system for Antimicrobial Resistance
Public Procurement of Innovation
About the project
The RaDAR project aims to address the European urgent need of a rapid detection and effective infection control system for antimicrobial resistance (AMR) through the implementation of a value-based cross-border collaborative procurement of innovative solutions.

Partners
RaDAR is composed of a cross-border Buyers Group of 4 public organisations from 3 different European countries (France, Spain and Italy). They collaborate as early adopters of innovative solutions to address common needs in facing the challenge of AMR.
Procurement
Anti-microbial resistance (AMR) is a significant and growing societal challenge. Innovation is needed to rapidly detect and control AMR in a number of settings, not least healthcare facilities and hospitals. The RaDAR project brings together healthcare buyers to undertake a collaborative procurement of rapid AMR detection and control systems.
Partners
RaDAR is composed of a cross-border Buyers Group composed of 4 public organisations from 3 different European countries (France, Spain and Italy) who will collaboratively work to act as early adopters and promote innovation, through the identification, evaluation and procurement of innovative solutions that will address their common needs related to one of the most important challenges that are currently present in the political agenda in EU and worldwide. Complementarily, a diverse and carefully selected supporting entities will ensure that the Buyers Group execute a procurement of innovative solutions that will meet both Consortium and individual needs.
Forum of interest in AMR
One of the missions of the RaDAR project is building awareness of the challenges of AMR, reaching a better coordination at EU level to tackle AMR, building strong partnerships, sharing experiences and aligning approaches. To respond to these proposed objectives, RaDAR has developed a Forum of Interest in AMR.


